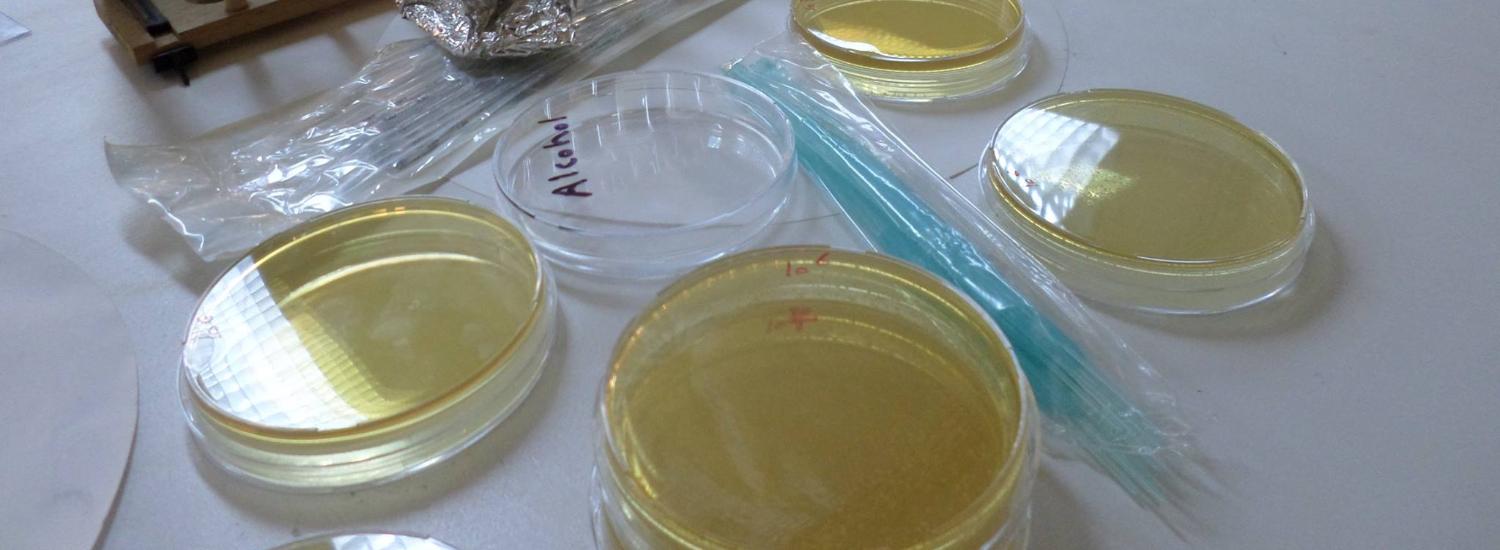
image

قسم الاحياء الدقيقة والمناعة
المزيد ...حول قسم الاحياء الدقيقة والمناعة
يعتبر قسم الأحياء الدقيقة والمناعة بكلية الصيدلة من الأقسام الرئسية التي تدرس علم الأحياء الدقيقة الصيدلانية والمناعة، في بداية أنشئ كلية الصيدلة كانت مقرارت القسم تدرس تحت إشراف قسم الصيدلة الصناعية إلى أن تم انشاء قسم الأحياء الدقيقة والمناعة في بداية التسعينات. يقوم قسم الأحياء الدقيقة والمناعة بتدريس مقررات الأحياء الدقيقة العامة والأحياء الدقيقة الصيدلانية وعلم المناعة الصيدلانية وكذلك مراقبة الجودة الميكروبيولوجية، كما يقوم القسم أيضا بالإشراف على تدريس مقررات الإحصاء واللغة العربية لطلاب الفصل (التمهيدي) الأول بكلية الصيدلة، هذا بالإضافة إلى تعاون القسم في المجال البحثي والتدريس الجامعي مع بعض الكليات المناظرة في الجامعات الليبية سواءً كان في مرحلة البكالوريوس أو مرحلة الدراسات العليا، وكذلك مع مركز مكافة الأمراض ومركز الرقابة على الأدوية والأغذية. كمـا يقوم القسم بتقديم الاستشارات والخبرات في مجالات الأحياء الدقيقة العامة والصيدلية والطبية والصناعية، كذلك يقدم القسم الخبرة الفنية وإجراء التحاليل اللازمة على مختلف العينات التي ترد إلى القسم في مجال الرقابة الجرثومية وتأكيد جودة التصنيع في كل ما يتعلق بالمستحضرات الصيدلانية وتقييم فاعلية التضاد الميكروبي للمضادات الحيوية وغير الحيوية، كما يحرص القسم على التعاون مع المراكز الصحية والمستشفيات العامة في مجال الأبحاث والاستشارات المتعلقة بعلم الأحياء الدقيقة الصيدلانية.
حقائق حول قسم الاحياء الدقيقة والمناعة
نفتخر بما نقدمه للمجتمع والعالم
المنشورات العلمية
هيئة التدريس
الطلبة
الخريجون
أخبار قسم الاحياء الدقيقة والمناعة
البرامج الدراسية
ماجستير - الاحياء الدقيقة
يوفر برنامج الماجستير في علم الاحياء الدقيقة فرصة لتزويد الطلاب بالمعرفة التخصصية والمهارات المختلفة في جميع جوانب علم الاحياء الدقيقة من التركيب الوظيفي والجزيئي للبكتيريا والفطريات والفيروسات والأمراض التى تسببها وعلاجها وكيفية التغلب عليها والوقاية منها مع ...
التفاصيلمن يعمل بـقسم الاحياء الدقيقة والمناعة
يوجد بـقسم الاحياء الدقيقة والمناعة أكثر من 14 عضو هيئة تدريس

أ. رحاب فؤاد سليمان الثلثي